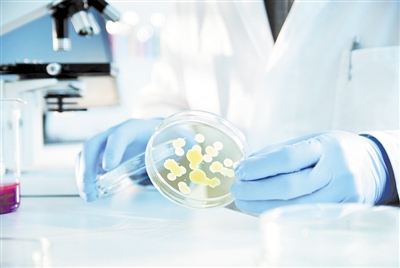

炣燃科技1月8日综合《科技日报》报道 近年来,由于广谱抗生素、抗菌药物的大量使用或滥用,各种耐药性细菌或真菌随之大量涌现,每年全球有近100万人死于无法用普通抗生素治疗的细菌感染;同时,由于新型抗菌药物研发能力不足,各种细菌本身耐药基因可横向传播,使现有抗生素的治疗效果大大降低, 人类有可能面临无有效抗生素可用的威胁。
为破解这一威胁,全球科学家一直在努力。日前,中科院昆明动物研究所天然药物功能蛋白质组学课题组赖仞研究员和张治业副研究员等人设计改造了一种强抗菌活性、高稳定性和低毒性的抗菌肽——ZY4,为应对当前越来越严重的耐药性鲍曼不动杆菌和绿脓杆菌的传播及感染问题提供了良好的候选药物分子,也为设计高效低毒的抗菌肽提供了参考新策略。研究成果在线发表于《美国国家科学院院刊》上。
来源:视觉中国
超级细菌威胁人类健康
我们知道,在与抗生素等药物长期、反复作用下,占多数的敏感菌株不断被杀灭,耐药菌株大量繁殖代替敏感菌株,使细菌对药物的耐药率不断升高;同时,耐药基因会在微生物间相互传播,导致了细菌或真菌耐药的情况越来越严重。人们将那些对多种抗生素具有耐药性的细菌形象地称为超级细菌。超级细菌不是特指某一种细菌,而是对演化了的多重耐药性细菌的泛称,这类细菌对现有抗生素具有强大的抵抗作用。
目前,受到广泛关注的超级细菌主要有耐甲氧西林金黄色葡萄球菌、耐多药肺炎链球菌、万古霉素肠球菌、多重耐药性结核杆菌、多重耐药鲍曼不动杆菌以及最新发现的携带有NDM-1基因的大肠杆菌和肺炎克雷伯菌等等。由于大部分抗生素对它们无能为力,因而对人类健康构成了极大危害。
2017年2月27日,世界卫生组织(WHO)在日内瓦发表了首份抗生素耐药“重点病原体”清单,这是一份对人类健康构成极大威胁的12种细菌种族目录。WHO指出,制定清单的用意在于指导和促进新型抗生素的研究与开发。
“这份清单是用来确保研发工作面向公共卫生紧急需求的新工具。抗生素耐药性问题不断加重,我们的治疗选用办法正在快速耗尽。如果仅仅依靠市场力量来解决问题,我们最迫切需要的新型抗生素将无法及时开发出来。”时任WHO系统和创新助理总干事玛丽-保罗·基尼博士表示。
抗菌肽杀菌快速且很难导致耐药
在世卫组织上述12种“超级细菌”清单中,鲍曼不动杆菌和绿脓杆菌被列为“极为重要”级。“鲍曼不动杆菌及绿脓杆菌典型的特性就是对碳青霉烯类药物耐药,是造成很多重病患者死亡的直接原因。”张治业告诉科技日报记者,对碳青霉烯类抗生素耐药的鲍曼不动杆菌和绿脓杆菌的出现,引起了人们对无法治疗的感染的担忧。
德国蒂宾根大学传染病处处长以及清单制定主要贡献者伊夫琳娜·塔科内利教授曾表示,针对这种病原体优先列表获得的新型抗生素将有助于减少世界各地因耐药感染造成的死亡。继续等待将会带来更多公共卫生问题,并对病人治疗产生很大影响。
中国科学家针对头号“超级细菌”主动出击。抗菌肽是一类具有抗菌活性的多肽类小分子,因其杀菌快速且很难导致微生物耐药受到全世界的关注,可用于新型抗菌候选药物分子的研发。赖仞研究员带领的团队识别了1000多个抗菌肽,并在此基础上进行了抗菌肽的结构功能改造,以提高抗菌活性、降低毒性和成本。ZY4是该团队最近设计改造的抗菌肽,具有强抗菌活性、高稳定性和低毒性。ZY4是一个由二硫键构成的环状肽,在体内具有很高的稳定性,半衰期为1.8小时,对耐药鲍曼不动杆菌和绿脓杆菌显示高效快速的杀菌活性。同时ZY4对这两种细菌的生物膜及滞留菌也有显著的清除作用,其综合抗菌效果明显优于妥布霉素、左氧氟沙星、卡那霉素及头孢替坦等传统抗生素。ZY4长期使用不易产生耐药性,亚抑菌浓度的ZY4与鲍曼不动杆菌和绿脓杆菌持续作用60代后,ZY4对这两类菌的抑菌作用未见明显改变。
值得注意的是,在小鼠败血症感染模型中,ZY4降低了对绿脓杆菌肺部感染的敏感性,也抑制了绿脓杆菌和鲍曼假单胞菌在靶器官的传播。这些发现表明,ZY4是抗多药物耐药细菌感染的理想候选药物分子。
ZY4抗菌肽源于自然超于自然
为提升对超级细菌的“作战”能力,科学家们一方面通过研发新型抗生素或抗菌分子,另一方面也改造传统的抗生素,使其活性得到提升或通过不同靶点发挥抗菌活性。遗憾的是,目前仅有少数几个新型抗生素处于临床开发阶段。与传统的抗生素不同,抗菌肽是一类由氨基酸组成的多肽类小分子,具有杀菌快速且很难导致微生物耐药等特性,是良好的抗菌候选药物分子。
“我们团队长期从事抗菌肽研究。截至目前,我们通过分离纯化结合基因鉴定及转录组分析等手段,鉴定识别了1000多个来自两栖类、爬行类及昆虫等动物体内的抗菌肽。”张治业告诉记者,近期,他们在天然抗菌肽的基础上,根据课题组多年的研究经验,并结合部分文献的报道,通过氨基酸的替换、结构修饰等手段,设计改造获得了ZY4。
张治业认为,改造抗菌肽的关键问题,是保持其已有的抗菌活性,并最大程度地减小毒性,增强稳定性,同时通过缩短肽链长度以实现成本最低化;而难点与创新点则在于如何提升抗菌肽的活性和增加特异性,这一方面来自于天然抗菌肽本身的特性,另一方面取决于不同细菌本身的性质,如革兰氏阴性菌和革兰氏阳性菌在细胞壁和细胞膜差别巨大,就可以根据这一特点,针对不同类型的细菌,通过设计改造来优化抗菌肽。
“用类似的方法并结合我们的经验,我们也希望开发出针对其他超级细菌的抗菌肽。”张治业表示,但ZY4作为候选药物分子,走向临床应用还有很长的路要走,还需要提供详细的药理、药效、毒理研究、药代动力学及药学研究等用于临床批文的申报;即使拿到了药物临床批文,也须经过Ⅰ期到Ⅲ期临床研究的考验。“我们的这项研究,其重要意义主要在于为应对当前越来越严重的耐药性鲍曼不动杆菌和绿脓杆菌的传播及感染问题提供了良好的候选药物分子,也为设计改造抗菌肽提供了思路和参考方法。”(记者 赵汉斌)
